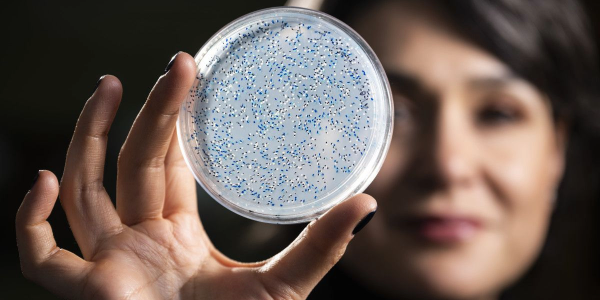
A woman with dark hair is holding up a petri dish and looking at it

Ready to make your mark?
Growing the Future
The University of Wisconsin-Madison College of Agricultural and Life Sciences is an engine of scientific discovery, with researchers working across the spectrum of agricultural and life sciences. Academically, the college offers research-based, hands-on teaching of undergraduates; world-class graduate programs rich in research and project assistantships; and short courses, workshops and other programs. Our outreach activities bring the work of the college to Wisconsin businesses, organizations and communities throughout the state. Learn more about CALS.
News

Society is becoming more health conscious with what they eat, and there is a lot of misinformation floating around. I think it’s imperative for educators and experts in the industry to inform consumers about health, food safety and quality.
Aaron Bodie
CALS Faces
Aaron Bodie
Aaron Bodie PhD’22 began his college career as a biology major at the University of Arkansas (UA). His fascination with food science started with a talk given by Steve Ricke. Ricke was a professor at UA at the time, and he hired Bodie as an undergraduate laboratory assistant. When Ricke took a position at CALS in 2020, Bodie enthusiastically accepted an offer to join Ricke’s lab there. Bodie focused his research on Campylobacter, a foodborne pathogen found in raw foods and became the first from Ricke’s MSABD lab to graduate with a Ph.D. Before accepting his current professorship at the University of Georgia, Bodie served as a food safety consultant. During that time, he also launched @dr.microfoodsafety on social media, where he posted information to help inform consumers. In 2023, the Alliance to Stop Foodborne Illness awarded Bodie a “40 Under 40” award. He recently launched @thebodielabgroup on Instagram to get his research out to the public.
$1.1M
Scholarships awarded in 2023-24
4,082
CALS students in 2023-24